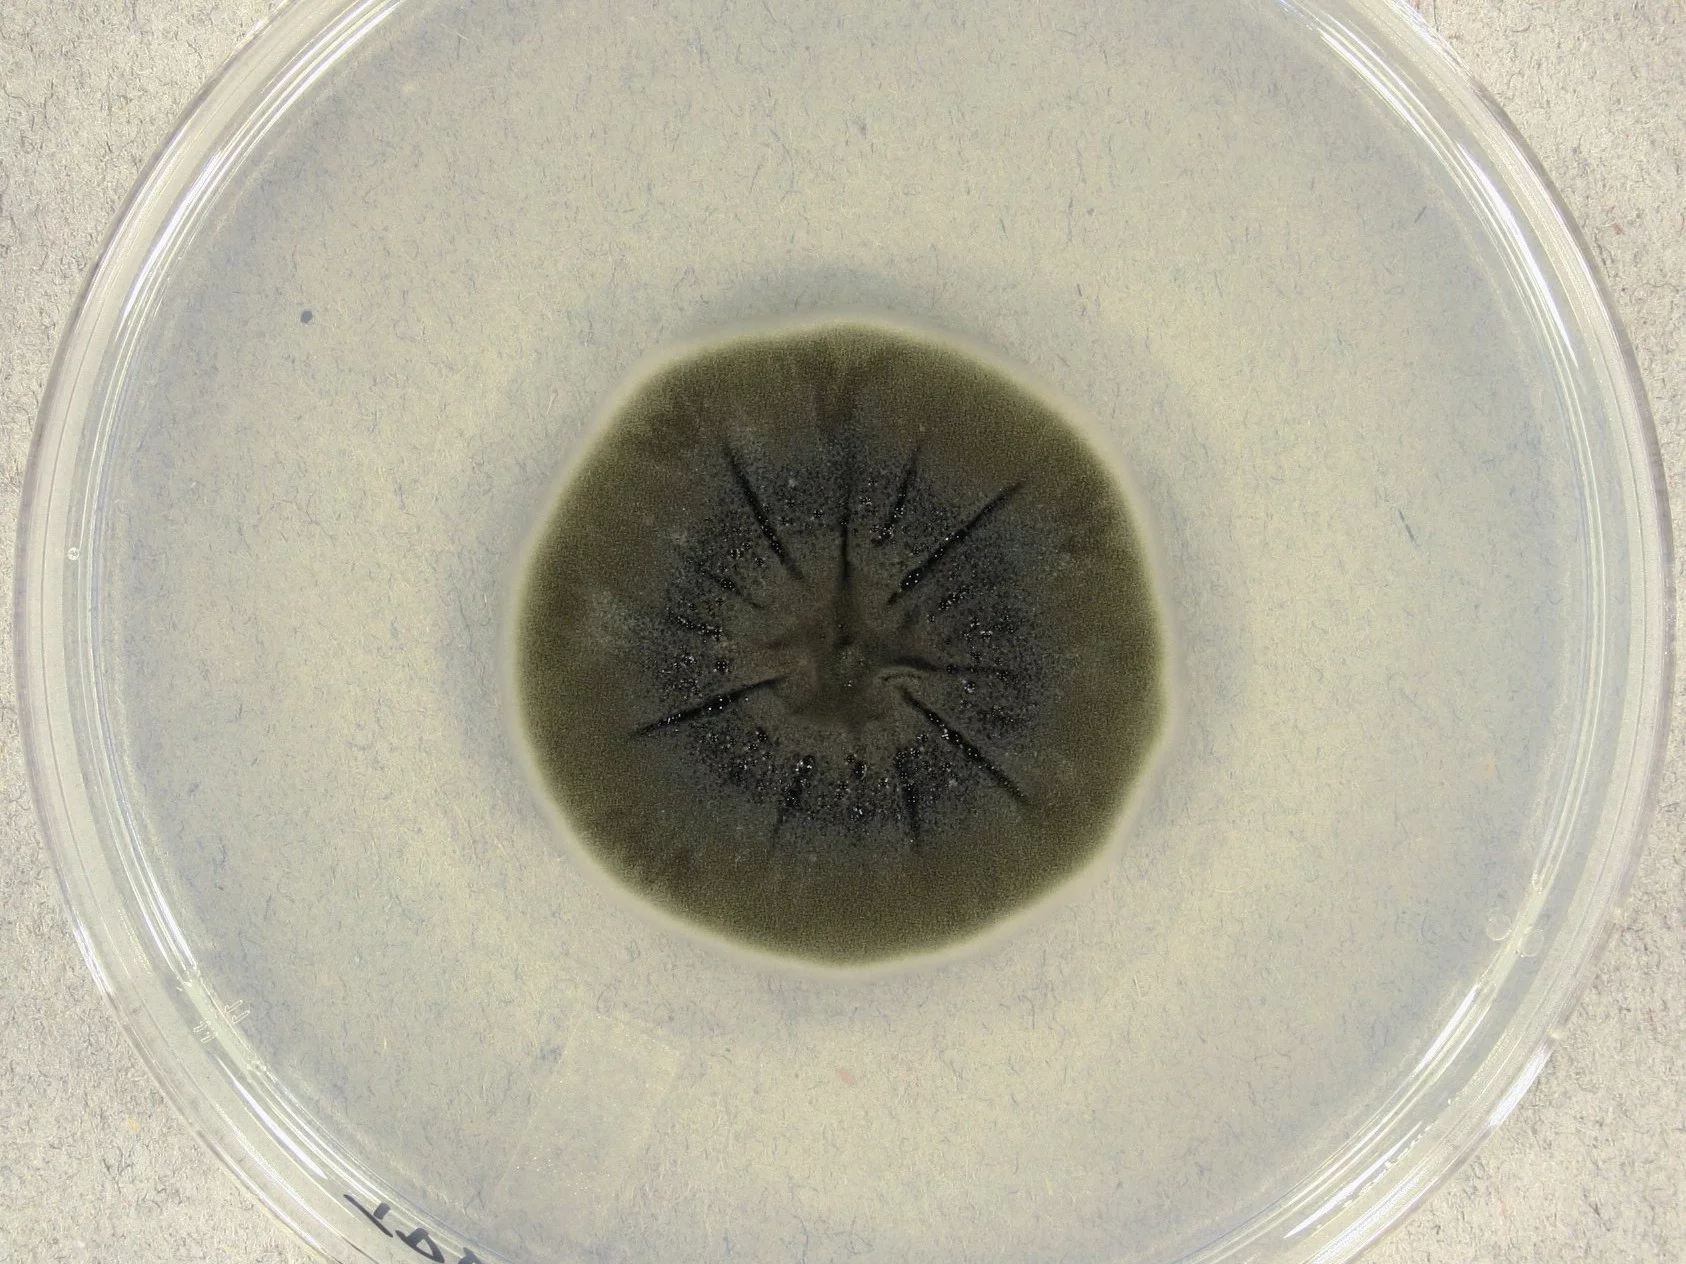
Cladosporium sphaerospermum

W latach 1997-98 wykryto rozległy wzrost grzybów na ścianach i innych konstrukcjach budowlanych we wnętrzach obudowy uszkodzonego bloku czwartego elektrowni jądrowej w Czarnobylu. Naukowcy znaleźli 47 gatunków grzybów. Dwa powszechnie występujące to Cladosporium sphaerospermum i Penicillium hirsutum. Niektóre grzyby zostały po raz pierwszy odnotowane w Ukrainie.
Porównanie gatunków rosnących zarówno w miejscach silnie, jak i stosunkowo słabo skażonych radioaktywnie wykazało dominację gatunków zawierających melaninę w miejscach silnie skażonych. Grzyby radiotroficzne posiadają zdolność do pochłaniania promieniowania jonizującego. To odkrycie daje nadzieję na zapewnienie astronautom ochrony przed szkodliwym promieniowaniem podczas podróży w kosmos – podało BBC.
Grzyby z melaniną rosły szybciej w obecności radioaktywnego cezu
Właściwości ochronne melaniny wykorzystywały również żaby w stawach wokół Czarnobyla. Były bardziej odporne i miały większą zdolność rozmnażania się, powoli zmieniając lokalną populację w czarną. W 2007 r. naukowcy odkryli, że grzyby z zawartością melaniny rosły o 10 proc. szybciej niż w obecności radioaktywnego cezu w porównaniu z tymi samymi grzybami hodowanymi bez promieniowania.
Tendencję do radiotrofizmu i pozytywnego wzrostu w obecności promieniowania wykazało jednak dziewięć gatunków grzybów melanizowanych zebranych w Czarnobylu. Jeśli chodzi o promieniowanie kosmiczne to jest ono „największym zagrożeniem” dla zdrowia astronautów podróżujących w przestrzeń kosmiczną. Nie stanowiło ono jednak problemu dla próbek Cladosporium sphaerospermum.
Zaskakujące odkrycie naukowców. Grzyb z Czarnobyla może pomóc w misjach kosmicznych
Grzyby zostały wysłane w grudniu 2018 r. na Międzynarodową Stację Kosmiczną. Naukowcy wykazali, że w przestrzeni kosmicznej rosną one jeszcze lepiej – średnio 1,21 razy. Kolejnym czynnikiem mogła być zerowa grawitacja. Eksperci przeprowadzili też testy z Cladosporium sphaerospermum jako materiałem ochronnym. Wraz z rozwojem tych grzybów rosła ilość zablokowanego promieniowania w porównaniu z próbkami bez grzybów.
Skuteczną ochroną była nawet smuga w szalce Petriego. Naukowcy sprawdzają, czy właściwości radioprotekcyjne wynikają z obecności innych składników biologicznych niż melanina. Jak na razie wydaje się jednak, że grzyby są najlepszą i najtańszą osłoną przed promieniowaniem w kontekście długoterminowych planów wysłania ludzi na Marsa.
Czytaj też:
Kosmiczna anomalia stulecia? Nowe dane o 3I/ATLAS budzą niepokójCzytaj też:
Uznański-Wiśniewski opowiedział o swoim marzeniu. Na pomysł wpadł na orbicie